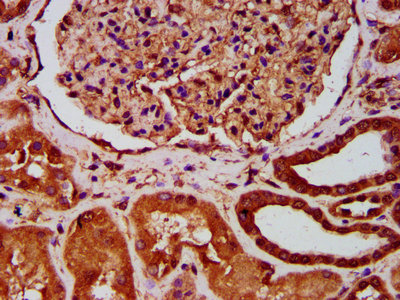

AVPR1A Antibody
-
中文名稱:AVPR1A兔多克隆抗體
-
貨號(hào):CSB-PA002468LA01HU
-
規(guī)格:¥440
-
圖片:
-
IHC image of CSB-PA002468LA01HU diluted at 1:400 and staining in paraffin-embedded human kidney tissue performed on a Leica BondTM system. After dewaxing and hydration, antigen retrieval was mediated by high pressure in a citrate buffer (pH 6.0). Section was blocked with 10% normal goat serum 30min at RT. Then primary antibody (1% BSA) was incubated at 4°C overnight. The primary is detected by a biotinylated secondary antibody and visualized using an HRP conjugated SP system.
-
Immunofluorescence staining of A549 cells with CSB-PA002468LA01HU at 1:133, counter-stained with DAPI. The cells were fixed in 4% formaldehyde, permeabilized using 0.2% Triton X-100 and blocked in 10% normal Goat Serum. The cells were then incubated with the antibody overnight at 4°C. The secondary antibody was Alexa Fluor 488-congugated AffiniPure Goat Anti-Rabbit IgG(H+L).
-
-
其他:
產(chǎn)品詳情
-
產(chǎn)品名稱:Rabbit anti-Homo sapiens (Human) AVPR1A Polyclonal antibody
-
Uniprot No.:
-
基因名:
-
別名:Antidiuretic hormone receptor 1a antibody; Arginine vasopressin receptor 1A antibody; AVPR 1 antibody; AVPR 1A antibody; AVPR V1a antibody; AVPR1 antibody; AVPR1A antibody; SCCL vasopressin subtype 1a receptor antibody; V1 vascular vasopressin receptor AVPR1A antibody; V1a vasopressin receptor antibody; V1aR antibody; V1AR_HUMAN antibody; Vascular/hepatic type arginine vasopressin receptor antibody; Vascular/hepatic-type arginine vasopressin receptor antibody; Vasopressin V1a receptor antibody
-
宿主:Rabbit
-
反應(yīng)種屬:Human
-
免疫原:Recombinant Human Vasopressin V1a receptor protein (1-52AA)
-
免疫原種屬:Homo sapiens (Human)
-
標(biāo)記方式:Non-conjugated
本頁(yè)面中的產(chǎn)品,AVPR1A Antibody (CSB-PA002468LA01HU),的標(biāo)記方式是Non-conjugated。對(duì)于AVPR1A Antibody,我們還提供其他標(biāo)記。見(jiàn)下表:
-
克隆類型:Polyclonal
-
抗體亞型:IgG
-
純化方式:>95%, Protein G purified
-
濃度:It differs from different batches. Please contact us to confirm it.
-
保存緩沖液:Preservative: 0.03% Proclin 300
Constituents: 50% Glycerol, 0.01M PBS, pH 7.4 -
產(chǎn)品提供形式:Liquid
-
應(yīng)用范圍:ELISA, IHC, IF
-
推薦稀釋比:
Application Recommended Dilution IHC 1:200-1:500 IF 1:50-1:200 -
Protocols:
-
儲(chǔ)存條件:Upon receipt, store at -20°C or -80°C. Avoid repeated freeze.
-
貨期:Basically, we can dispatch the products out in 1-3 working days after receiving your orders. Delivery time maybe differs from different purchasing way or location, please kindly consult your local distributors for specific delivery time.
-
用途:For Research Use Only. Not for use in diagnostic or therapeutic procedures.
引用文獻(xiàn)
- Terlipressin combined with conservative fluid management attenuates hemorrhagic shock-induced acute kidney injury in rats LUC Castro,Scientific reports,2022
相關(guān)產(chǎn)品
靶點(diǎn)詳情
-
功能:Receptor for arginine vasopressin. The activity of this receptor is mediated by G proteins which activate a phosphatidyl-inositol-calcium second messenger system. Has been involved in social behaviors, including affiliation and attachment.
-
基因功能參考文獻(xiàn):
- Study finds evidence of differential allele expression, in at least a third of human brain samples heterozygous for a reporter single nucleotide polymorphism (SNP) in the arginine vasopressin receptor 1a (AVPR1a) transcript. We also show that this functional effect and a downstream phenotype, externalizing behavior, are predicted by AVPR1a short tandem repeats but not SNPs. PMID: 29581423
- Despite having a similar minor allele frequency (MAF) of 14.5% compared with the SMILE cohort, our results did not support an association of the mirSNP rs11174811 with the hypertension phenotype or with continuous blood pressure outcomes in the south Indian population. PMID: 29182374
- The data of this study indicated that alterations in amygdala signalling may constitute a neural mechanism by which polymorphisms of the AVPR1A gene could influence ASD susceptibility. PMID: 28322981
- These results demonstrate that polymorphisms in the AVPR1A promoter region might be involved in pathophysiology of ASD and in functional regulation of the expression of AVPR1A. PMID: 28808521
- Overall, our study establishes continuity between the existing AVPR1a research in clinical and non-clinical populations. Our results suggest that vasopressin may exert its effects on social behaviour in part by modulating attentional focus between social and non-social cues. PMID: 27874273
- Three OXTR polymorphisms (rs2270465, rs2268493, rs7632287) and 2 AVPR1A polymorphisms (rs1587097, rs1042615) showed nominal effects (p < .05) on vocal symptoms, of which 1 (rs1587097) remained significant after correcting for multiple testing (p = .003). Study found potential mediation of the effect of the OXTR rs2268493 polymorphism on vocal symptoms through levels of cortisol. PMID: 28687839
- Using a mixed mediation and moderation model, study found that the gray matter volume of the right fusiform face area mediated the association between AVPR1A RS3 and altruistic behavior. Moreover, this mediation effect was significant only in male subjects. PMID: 27027249
- Genetic variation in the vasopressin 1a receptor was found not to be associated with circulatory or renal failure, but with the presence of coagulation failure in patients with acute decompensation of liver cirrhosis and acute-on-chronic liver failure. PMID: 28350742
- The gene-based analysis indicated association of variation within AVPR1A with aggressive behavior. We conclude that common variants at 2p12 show suggestive evidence for association with childhood aggression. PMID: 26087016
- Association between neural activation of the anterior prefrontal cortex in mothers and fathers in response to their child smiling video stimuli to induce the positive affect related to attachment with their child, and genetic variants of OT receptor (OXTR) and AVP receptor 1A (AVPR1A). PMID: 27743766
- Study used brainstem tissue containing this region in order to validate a reliable, pharmacologically informed receptor autoradiography protocol for use in human brain tissue more broadly and to establish where OXTR and AVPR1a are expressed in adjacent regions in the human brainstem. PMID: 26911439
- Mothers with long alleles for AVPR1a and DRD4 engaged in more mother-oriented social cognition, which in turn predicted less sensitive maternal behavior. There were no significant direct effects of AVPR1a or DRD4 on maternal sensitivity (beta = 0.02, P = .73 and beta = -0.10, P = .57, respectively). PMID: 27581946
- The arginine vasopressin receptor 1A gene (AVPR1A) is known to affect social communication and has been reported to associate with autism in several studies. PMID: 25707602
- examined associations between polymorphisms in OXTR and AVPR1a and individual differences in emotional and cognitive empathy 367 young adults; emotional empathy was associated solely with OXTR, whereas cognitive empathy was associated solely with AVPR1a PMID: 25476609
- AVPR1A RS3 was not associated with schizophrenia; variation in the AVPR1A gene contributes to social behavioral deficits associated with schizophrenia PMID: 25529259
- Study identified, in OXTR and AVPR1A genes, signatures of balancing selection in the cis-regulative acting sequences such as transcription factor binding and enhancer sequences, as well as in a transcriptional repressor sequence motif. Additionally, in the intron 3 of the OXTR gene, the SNP rs59190448 appears to be under positive directional selection. PMID: 25968600
- Haplotype analysis revealed an association of AVPR1A C*S- and C*L-haplotype (rs11174811 and RS1, respectively) and increased or decreased Extraversion (EPI) in Bashkirs, respectively. PMID: 25438555
- Study found that variability in the rs7298346 marker, located in the 5'-flanking region, was related to a composite measure of executive functioning in 4-year-old children after controlling for a variety of covariates and children's theory of mind. PMID: 25016245
- Gene-level tests showed that DRD2 was associated with vocabulary, ASPM with vocabulary and reading decoding, and AVPR1A with all three endophenotypes. PMID: 24849541
- humanized AVPR1A mice displayed increased reciprocal social interactions compared with wild-type animals. PMID: 24924430
- Early caregiving combined with genetic liability along the axis of vasopressin-oxytocin gene pathways: G x E contributions to PTSD. PMID: 24618689
- Men, but not women, with high levels of poststressor AVP and the 320 allele of the RS1 polymorphism reported more poststressor anger than noncarriers. PMID: 24660771
- There was moderate statistical evidence for interactions shoulder pain phenotypes between AVPR1A and depressive symptoms, pain catastrophizing, or kinesiophobia PMID: 24373571
- The results of this study found a statistically significant association between microsatellites and Korean autism spectrum disorders. PMID: 20452058
- Human maternal behaviour is associated with arginine vasopressin receptor 1A gene PMID: 22764113
- In a sample of European mothers, a microsatellite variant RS3 of the vasopressin 1a receptor gene is associated with maternal sensitivity; this association is strongest under conditions of high maternal early adversity. PMID: 22288734
- greater perceived threat predicted lower commitment to civic duty for individuals with one or two short alleles for AVPR1a rs1, but not for individuals with only long alleles PMID: 22457427
- analysis of AVPR1A and SLC6A4 polymorphisms in choral singers and non-musicians PMID: 22384070
- data suggest a possible interrelation between AVR and RS3 gene variants of the AVPR1A gene and impulsive aggression in patients with borderline personality disorder PMID: 22008661
- AVPR1A variant associated with preschoolers' lower altruistic behavior. PMID: 21980412
- Our results demonstrate a role for V1A-mediated signaling in the development of heart failure. PMID: 21747049
- report finds an association between AVPR1A and the risk for DUD. PMID: 21514569
- The importance of subtle, quantitative measures of endophenotype are emphasized in this review of the neural distribution of vasopressin 1a receptor (V1aR), a recent focus for studies of social behavior. PMID: 20889332
- A positive association between the AVPR1A haplotype (RS1 and AVR) and active current listening to music (permuted P=0.0019) was observed. PMID: 21307861
- Possible roles of oxytocin receptor and vasopressin-1alpha receptor in the pathomechanism of dysperistalsis and dysmenorrhea in patients with adenomyosis uteri. PMID: 20413116
- Evidence provided for a possible association between these SNPs and the phenotype of autism spectrum disorders. PMID: 20546835
- polymorphism rs1042615 of the V1a receptor altered body mass index and diastolic pressure in middle-aged and older men and the training-induced responses of DBP and low-density lipoprotein cholesterol, whereas women did not show any of these responses PMID: 20142561
- transmission disequilibrium testing of polymorphism in autism PMID: 12082568
- residue Phe225, located in transmembrane domain V, directly participates in the binding of the V1a-selective nonpeptide antagonist SR49059 PMID: 12869559
- In the wildtype V1aR, Arg46 constrains the inactive conformation of the receptor; on binding AVP this constraint is alleviated, promoting the transition to active V1aR PMID: 14622255
- examination of interaction with beta-arrestin and trafficking patterns by heterodimerization with V2 vasopressin receptor PMID: 14757828
- AVPR1a's exons were screened in 125 independent autistic probands. 2 promoter polymorphisms were typed in 65 autism-affected sibling-pair families. Linkage & linkage disequilibrium were seen in a subset with relatively less severe language impairment. PMID: 15098001
- Glu54 is critical for arginine vasopressin binding by V1aR. PMID: 15994199
- Association between AVPR1a and SLC6A4 reflects the social communication, courtship, and spiritual facets of the dancing phenotype. PMID: 16205790
- This study confirms an association between the AVPR1a gene and autism spectrum disorders and identifies a third microsatellite associated with autism spectrum disorders as well as haplotypes consisting of all three markers. PMID: 16520824
- analysis of a pharmacological chaperone ligand that acts on misfolded mutant V(1a) receptors PMID: 16565083
- These results suggest that the four SNPs in the promoter region of the V1aR gene may not be useful as genetic markers for platelet aggregation heterogeneity. PMID: 16721832
- There is an association of the V1aR SNP-6951 with essential hypertension in nonobese individuals. PMID: 17653244
- This gene contributes to social bonding in lower animals and in human behavior, suggesting a common evolutionary mechanism. PMID: 17696996
- study is the first to report associations between AVPR1A and OXTR genetic variation with life history traits in humans PMID: 17939166
顯示更多
收起更多
-
亞細(xì)胞定位:Cell membrane; Multi-pass membrane protein.
-
蛋白家族:G-protein coupled receptor 1 family, Vasopressin/oxytocin receptor subfamily
-
數(shù)據(jù)庫(kù)鏈接:
Most popular with customers
-
-
YWHAB Recombinant Monoclonal Antibody
Applications: ELISA, WB, IHC, IF, FC
Species Reactivity: Human, Mouse, Rat
-
Phospho-YAP1 (S127) Recombinant Monoclonal Antibody
Applications: ELISA, WB, IHC
Species Reactivity: Human
-
-
-
-
-